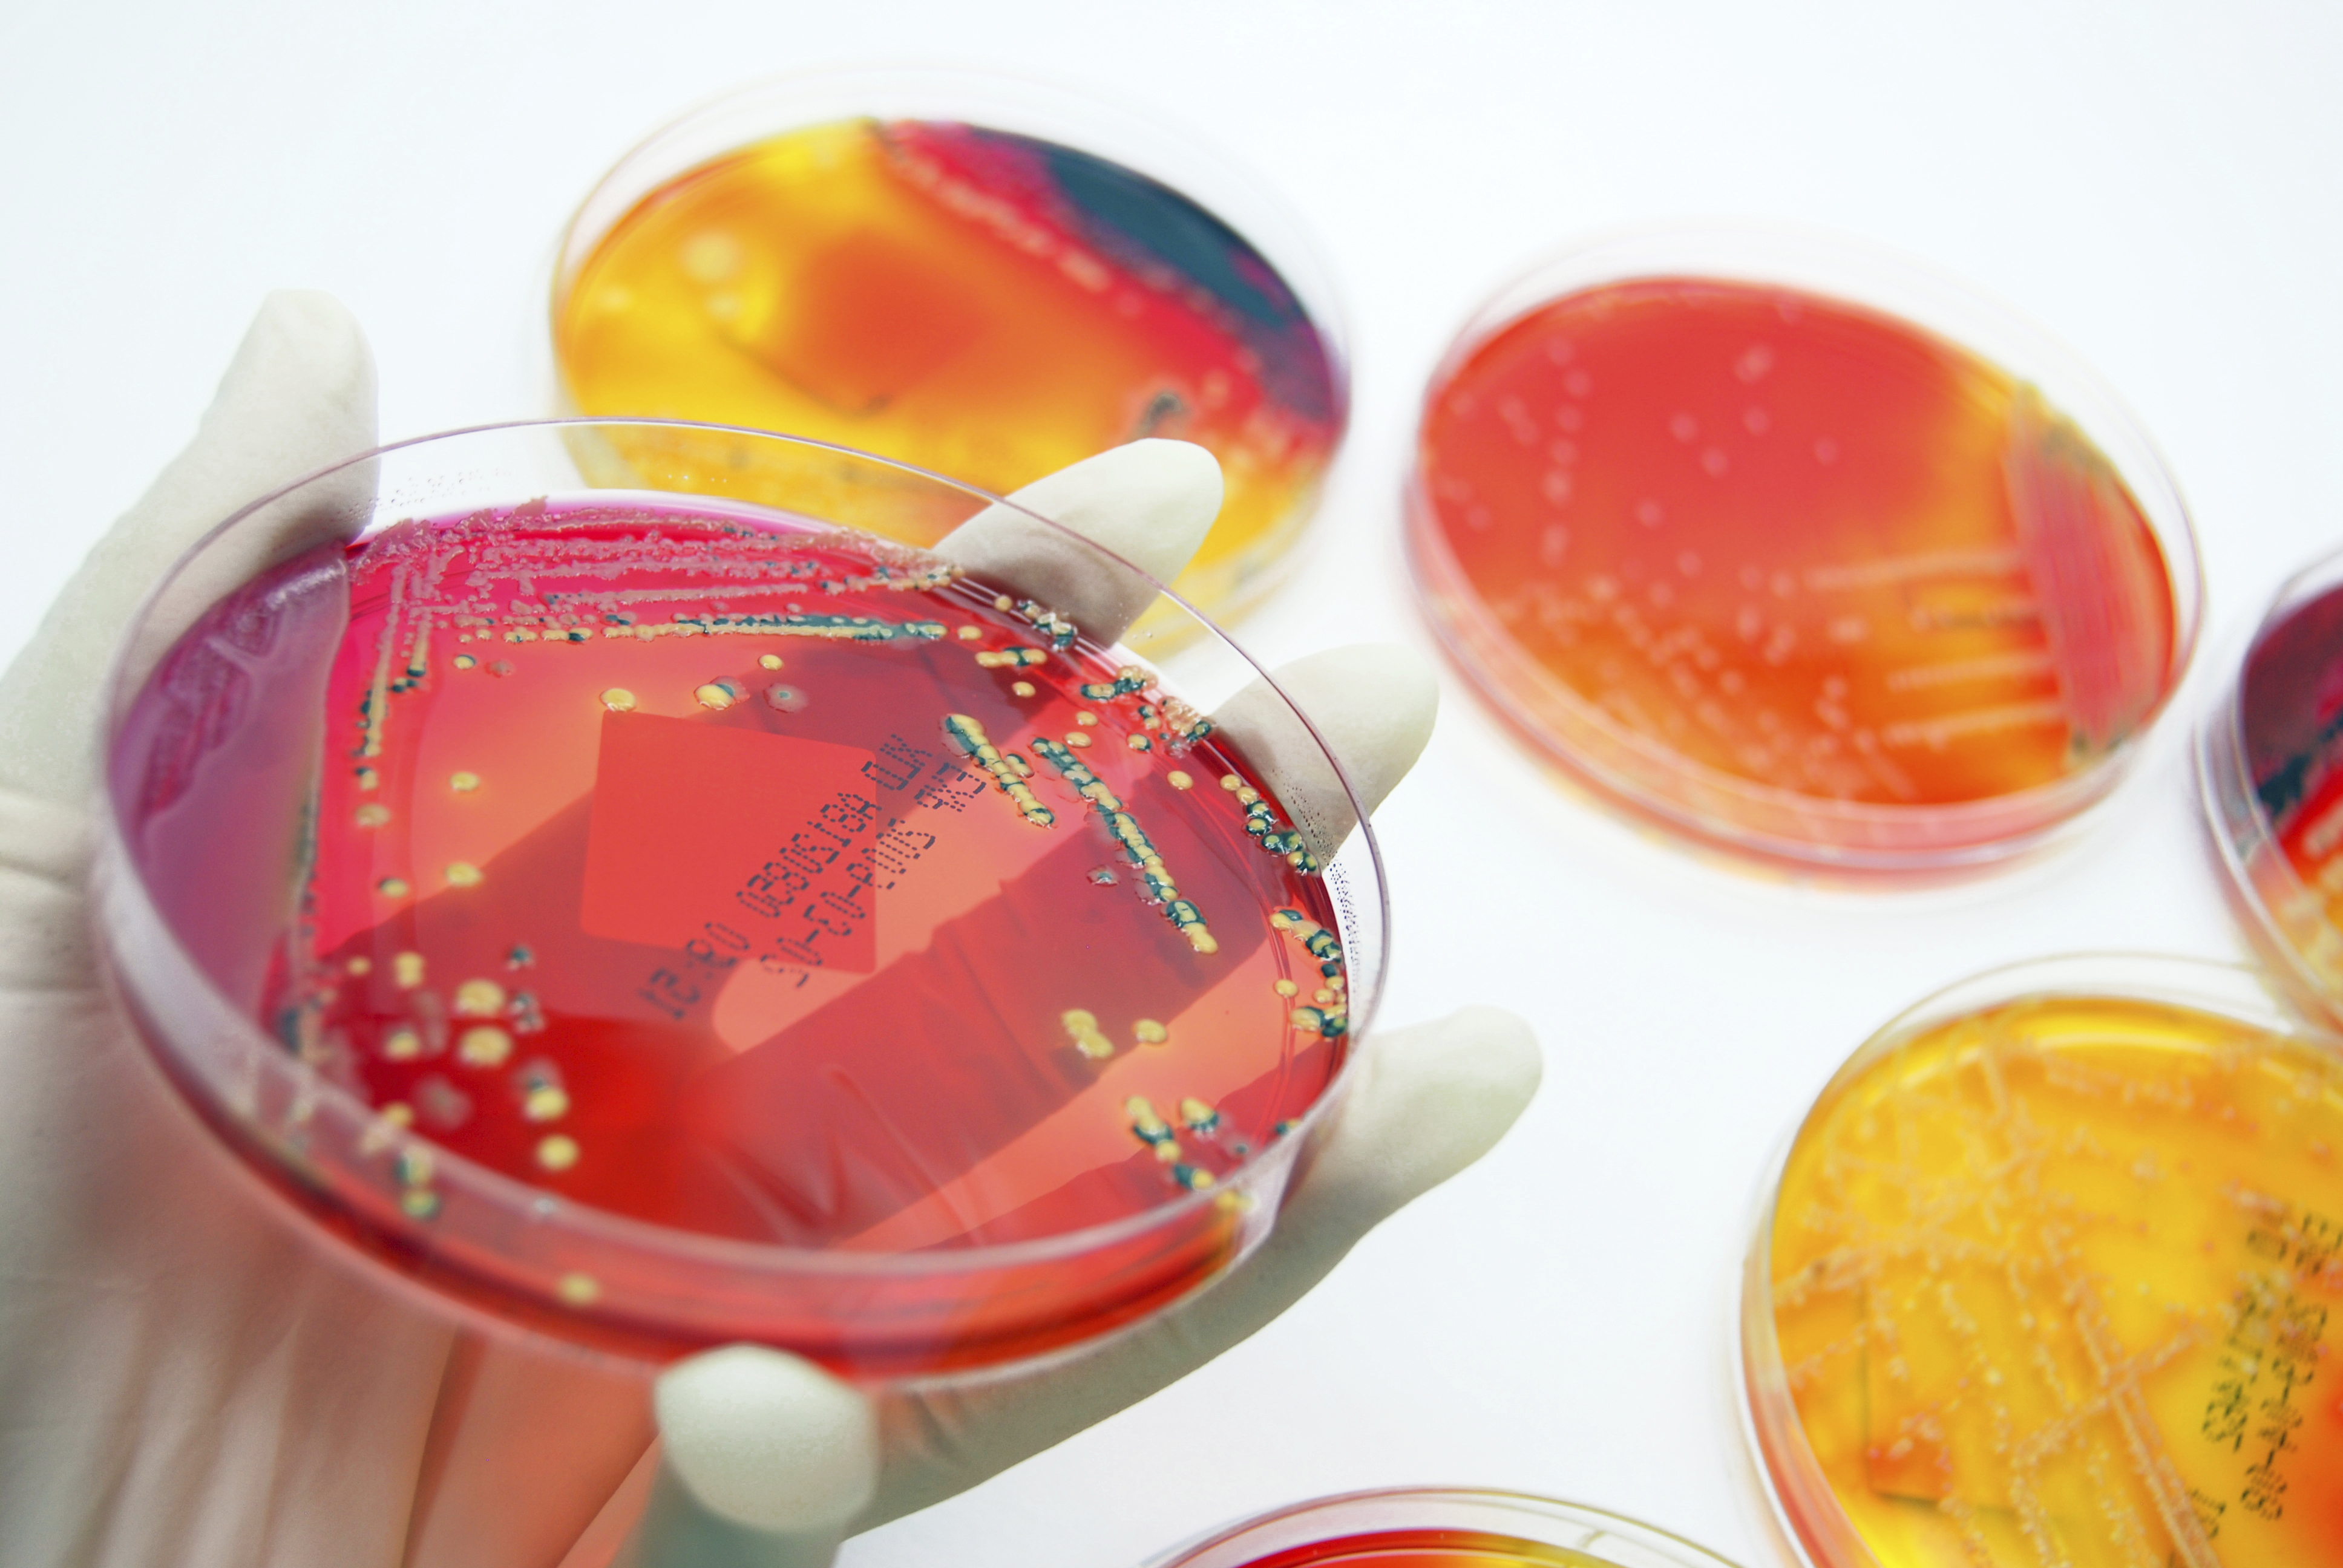
Bilde av bakterier som vokser på skål

Økning i resistente bakterier i Norge
Foto: ECDC
FHIs årsrapport for 2024 om forekomst av resistente bakterier og sopp med spesiell betydning for smittevern i helsetjenesten i Norge viser en økning i resistente bakterier. Mest bekymringsfullt er økningen på 21% siste året for karbapenemase-produserende bakterier, det vil si bakterier som er resistente for de mest bredspektrede midlene. Rapporten viser også en tilnærmet dobling av antall personer med resistente enterokokker, hovedsakelig pga. et utbrudd av vankomycinresistente enterokokker (VRE) på helseinstitusjoner på østlandet.
Les FHIs omtale av rapporten her: Fortsatt markant økning av antibiotikaresistente bakterier - FHI
Les NRKs omtale av saken her: FHI med nye tall: Stadig flere blir smittet av resistente bakterier – NRK